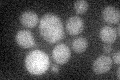
YER165W
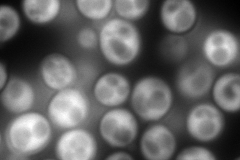
YER165W
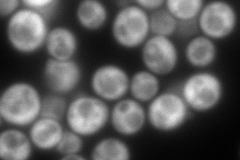
YER165W
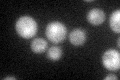
YER165W
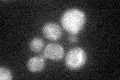
YER165W

View description
Poly(A) binding protein, part of the 3'-end RNA-processing complex, mediates interactions between the 5' cap structure and the 3' mRNA poly(A) tail, involved in control of poly(A) tail length, interacts with translation factor eIF-4G
Localization:
Intensity:
Fold change:
Significance:
-
C’ GFP library in SD
below threshold19.17 -
N' NOP1pr-GFP in SD
cytosol678.844 -
N' TEF2pr-mCherry in SD
cytosol357.559 -
N' NATIVEpr-GFP in SD

cytosol547.332 -
N' TEF2pr-VC and Cyto-VN in SD

#N/A0 -
C’ GFP library in SD+DTT
cytosol19.571.02No -
C’ GFP library in SD+H2O2
cytosol20.011.04No -
C’ GFP library in Starvation Media

cytosol15.390.8No -
C’ GFP library on the background of Pup2-DaMP

N/A -
C’ GFP library on the background of CCT mutant

N/A0N/AYes
